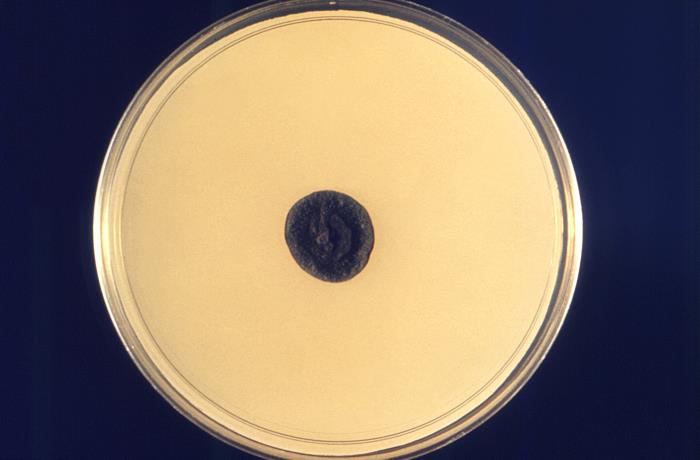

Migrény, paralýza tváre i porážka. Mužovi žije v mozgu vzácna čierna pleseň, ako jeden z mála s ňou ešte žije
- Muž z Rhode Islandu Tyson Bottenus trpí vzácnou dematóznou hubou, ktorá sa tiež nazýva aj ako „čierna pleseň“
- Hubou sa nakazil na výlete v Kostarike, teraz sa nachádza v jeho mozgu. Chirurgicky sa nedá odstrániť
- Trvalo viac ako 8 mesiacov, kým doktori odhalili pravú príčinu mužových problémov
- Bottenus trpel intenzívnymi bolesťami hlavy, prekonal aj sériu mozgových príhod
- Muž z Rhode Islandu Tyson Bottenus trpí vzácnou dematóznou hubou, ktorá sa tiež nazýva aj ako „čierna pleseň“
- Hubou sa nakazil na výlete v Kostarike, teraz sa nachádza v jeho mozgu. Chirurgicky sa nedá odstrániť
- Trvalo viac ako 8 mesiacov, kým doktori odhalili pravú príčinu mužových problémov
- Bottenus trpel intenzívnymi bolesťami hlavy, prekonal aj sériu mozgových príhod
Začalo sa to migrénami, na ktoré nezaberali lieky na bolesť. Tyson Bottenus z Rhode Islandu preto začal brať doslova hrste liekov proti bolesti. Bolesti ale neustúpili a postupne sa pridali ďalšie príznaky ako paralýza časti tváre a dve lézie na mozgu, ktoré doktori spočiatku považovali za nádorové ložiská. Experti postupne vylúčili lymskú boreliózu, tuberkulózu, HIV i rakovinu mozgu.
Až tretia biopsia odhalila, že ide o zriedkavú pleseň, ktorá mužovi narástla v mozgu, uvádza lokálny denník The Providence Journal, ktorý pokrýva dianie v Providence a Rhode Island (USA).
„Lekári boli prekvapení, pretože huba Cladophialophora bantiana je taká vzácna,“ povedal Bottenus pre denník. „Prvé dve biopsie mozgu boli neúspešné, ale tá tretia, namiesto toho, aby našli rakovinu mozgu, na ktorú mali podozrenie, našla na mojom mozgu rastúcu čiernu pleseň. Moja neurochirurgička povedala, že to doslova vidí.“
Lekári neskôr dospeli k záveru, že muž chytil Cladophialophora bantiana, ktorá sa prezýva aj „čierna pleseň“ na výlete v Kostarike.
Čo vieme o Cladophialophora bantiana:
Cladophialophora bantiana alebo C. bantiana je je dematózna huba, o ktorej je známe, že spôsobuje mozgové abscesy u ľudí. Podľa štúdie uverejnenej na webe Národnej lekárskej knižnice Spojených štátov amerických, lekári zaznamenali doteraz len 120 prípadov nákazy „čiernou piesňou“.
Väčšina z nich (70 %) bola zaznamenaná u mužov vo veku do 35 rokov. Často u ľudí so zníženou imunitou. Najviac nákaz bolo zaznamenaných v subtropických oblastiach, ale môže sa vyskytovať aj v miernych klimatických pásmach. Vedci doteraz nevedia, ako vstupuje do tela, myslia si, že cestu do mozgu si môže nájsť prostredníctvom rán a krvou potom putovať až do mozgu. Možná je aj inhalácia prostredníctvom dýchacích ciest človeka.
Úmrtnosť je približne 65 %, pričom v minulosti sa pohybovala až na 100 %. Liečba pozostáva z chirurgického zákroku, ktorý odstráni léziu v mozgu a následnej antimykotickej liečbe, prostredníctvom protiplesňových liekov. Ak sa lézia nedá chirurgicky odstrániť, nasadia sa antimykotiká a iné liečivá. Úspešnosť liečby a nižšia úmrtnosť je preukázaná pri pacientoch, ktorým sa podarilo odstrániť léziu. Všetci pacienti, ktorí nepodstúpili žiadnu liečbu, umreli.
Bottenus trávil výlet v Kostarike bicyklovaním. Doktori nevedia s určitosťou zistiť, či hubu inhaloval pri bicyklovaní na prašných cestách exotickej krajiny, alebo sa mu dostala do krvného obehu pri páde na bicykli, kde si poranil lakeť.
Tak či onak, huba putovala do jeho mozgu, kde odvtedy žije. Pár týždňov po návrate domov sa objavili, u vtedy 31-ročného Bottenusa, intenzívne bolesti hlavy a ochrnutie tvárových svalov. Kvôli bolesti musel opustiť zamestnanie kapitána lode v Newporte.
„Môj život sa za menej ako rok drasticky zmenil,“ napísal v článku pre Buzzfeed. „Moja jachtárska kariéra sa náhle skončila. Kým predtým som bol silný a sebavedomý jazdec na bicykli, teraz som často bezdôvodne padal. Zdalo sa, že som stratil rovnováhu spolu so všetkým ostatným.“
Streoidy vynechal, dostal sériu porážok
Osem mesiacov po prvých príznakoch bol prijatý do Massachusetts General Hospital v Bostone, kde neurochirurgička zbadala tmavú hmotu. Texaské laboratórium potvrdilo, že Bottenus má extrémne vzácnu tropickú hubu.
Žiaľ, léziu s hubou nebolo možné chirurgicky odstrániť, pretože bola hlboko v mozgu, v citlivých a dôležitých častiach. Lekári preto začali liečbu kombináciou protiplesňových liekov a steroidov, ktoré mali kontrolovať opuch v mozgu.
Keď svet zasiahla pandémia koronavírusu, Bottenus prestal užívať steroidy v obave, že liek oslabí jeho imunitný systém. Lekárov o vysadení lieku neinformoval.
„Moja viera v modernú medicínu bola na historickom minime,“ priznal. Hazardovanie sa mu ale nevyplatilo.
O týždeň neskôr dostal sériu menších mozgových príhod a sanitkou ho rýchlo previezli do nemocnice. I keď porážky prežil, zanechali na ňom stopy. Jeho hlas zhrubol, zmenil sa mu rukopis a objavilo sa dvojité videnie.
Chirurgický zákrok mu opravil videnie, ale stále nemôže riadiť auto ani sa plaviť na lodi. „Môj hlas je stále zvláštny a moja krátkodobá pamäť nie je dobrá. Nemôžem ísť po ulici bez toho, aby som sa nestratil, ale dokážem napísať 20 strán,“ povedal Bottenus, ktorý sa nevzdáva a dokonca začal postgraduálne štúdium. Momentálne podstupuje liečbu novými antimykotikami.
Čítaj viac z kategórie: Zahraničie
Zdroje: The Providence Journal, US National Library of Medicine National Institutes of Health, Buzzfeed